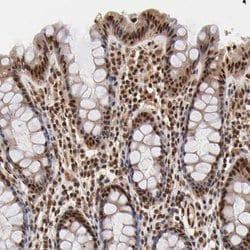
Invitrogen MED12 Polyclonal Antibody 100 &mu;L; Unconjugated:Antibodies,

missing translation for 'onlineSavingsMsg'
Learn More
Learn More
Invitrogen™ MED12 Polyclonal Antibody


Rabbit Polyclonal Antibody
Brand: Invitrogen™ PA551851
This item is not returnable.
View return policy
Description
Immunogen sequence: RLLLYHTHLR PRPRAYYLEP LPLPPEDEEP PAPTLLEPEK KAPEPPKTDK PGAAPPSTEE RKKKSTKGKK RSQPATKTED YGMGPGRSGP YGVTVPPDLL HHPNPGSITH LNYRQGSIGL YTQNQ Highest antigen sequence identity to the following orthologs: Mouse - 94%, Rat - 94%.
The initiation of transcription is controlled in part by a large protein assembly known as the preinitiation complex. A component of this preinitiation complex is a 1.2 MDa protein aggregate called Mediator. This Mediator component binds with a CDK8 subcomplex which contains the protein encoded by this gene, mediator complex subunit 12 (MED12), along with MED13, CDK8 kinase, and cyclin C.
Specifications
| MED12 | |
| Polyclonal | |
| Unconjugated | |
| Med12 | |
| 230kDa; activator-recruited cofactor 240 kDa component; ARC240; CAG repeat protein 45; CAGH45; FGS1; HOPA; human opposite paired; Kiaa0192; Med12; MED12S; Mediator complex subunit 12; mediator of RNA polymerase II transcription subunit 12; mediator of RNA polymerase II transcription, subunit 12 homolog; Mopa; OHDOX; OKS; OPA1; OPA-1; OPA-containing protein; OPA-containing protein 1; putative mediator subunit 12; thyroid hormone receptor-associated protein complex 230 kDa component; thyroid hormone receptor-associated protein, 230 kDa subunit; TNRC11; TRAP230; trinucleotide repeat containing 11 (THR-associated protein); trinucleotide repeat containing 11 (THR-associated protein, 230 kDa subunit); trinucleotide repeat-containing gene 11 protein | |
| Rabbit | |
| Antigen affinity chromatography | |
| RUO | |
| 9968 | |
| Store at 4°C short term. For long term storage, store at -20°C, avoiding freeze/thaw cycles. | |
| Liquid |
| Immunohistochemistry (Paraffin) | |
| 0.1 mg/mL | |
| PBS with 40% glycerol and 0.02% sodium azide; pH 7.2 | |
| Q93074 | |
| Med12 | |
| Recombinant protein corresponding to Human MED12. Recombinant protein control fragment (Product #RP-92261). | |
| 100 μL | |
| Primary | |
| Human | |
| Antibody | |
| IgG |
Product Content Correction
Your input is important to us. Please complete this form to provide feedback related to the content on this product.
Product Title
Spot an opportunity for improvement?Share a Content Correction